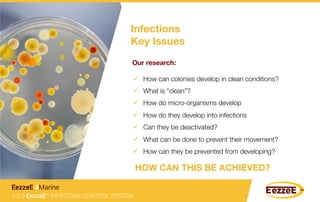
Infections
Key Issues 
Our research: 
ü  How can colonies develop in clean conditions?
ü  What is “clean”?
ü  How do micro-organisms develop
ü  How do they develop into infections
ü  Can they be deactivated?
ü  What can be done to prevent their movement?
ü  How can they be prevented from developing?
HOW CAN THIS BE ACHIEVED?
1-2-3 EezzeE™ INFECTION CONTROL SYSTEM
EezzeE 4Marine
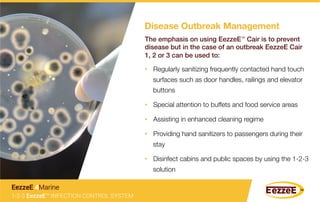
The emphasis on using EezzeE™ Cair is to prevent
disease but in the case of an outbreak EezzeE Cair !
1, 2 or 3 can be used to:!
•  Regularly sanitizing frequently contacted hand touch
surfaces such as door handles, railings and elevator
buttons
•  Special attention to buffets and food service areas
•  Assisting in enhanced cleaning regime
•  Providing hand sanitizers to passengers during their
stay
•  Disinfect cabins and public spaces by using the 1-2-3
solution
Disease Outbreak Management
1-2-3 EezzeE™ INFECTION CONTROL SYSTEM
EezzeE 4Marine

The document describes a 1-2-3 infection control system from EezzeE Marine. It discusses the problems with current disinfection methods, including resistance to some disinfectants and the difficulty in removing biofilms. The 1-2-3 system includes a hydrogen peroxide and silver solution to clean and remove biofilms in stage 1. In stage 2, a quaternary ammonium compound disinfectant is used. Finally in stage 3, a long-lasting protective coating is applied. The system aims to greatly reduce microorganisms on surfaces and prevent infections.